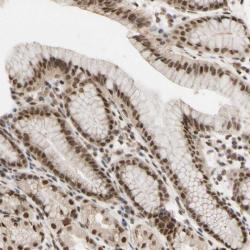

Antibody data
- Antibody Data
- Antigen structure
- References [4]
- Comments [0]
- Validations
- Western blot [1]
- Immunohistochemistry [1]
Submit
Validation data
Reference
Comment
Report error
- Product number
- sc-15408 - Provider product page

- Provider
- Santa Cruz Biotechnology
- Proper citation
- Santa Cruz Biotechnology Cat#sc-15408, RRID:AB_2061023
- Product name
- Anti-ATRX
- Antibody type
- Polyclonal
- Antigen
- Recombinant full-length protein
- Reactivity
- Human
- Host
- Rabbit
Submitted references ATRX ADD domain links an atypical histone methylation recognition mechanism to human mental-retardation syndrome
The death-associated protein DAXX is a novel histone chaperone involved in the replication-independent deposition of H3.3.
Regulation of ICP0-null mutant herpes simplex virus type 1 infection by ND10 components ATRX and hDaxx.
Herpes simplex virus type 1 genomes are associated with ND10 nuclear substructures in quiescently infected human fibroblasts.
Shigeki Iwase, Bin Xiang, Sharmistha Ghosh, Ting Ren, Peter W Lewis, Jesse C Cochrane, C David Allis, David J Picketts, Dinshaw J Patel, Haitao Li, Yang Shi
Nature Structural & Molecular Biology 2011 Jun;18(7):769-776
Nature Structural & Molecular Biology 2011 Jun;18(7):769-776
The death-associated protein DAXX is a novel histone chaperone involved in the replication-independent deposition of H3.3.
Drané P, Ouararhni K, Depaux A, Shuaib M, Hamiche A
Genes & development 2010 Jun 15;24(12):1253-65
Genes & development 2010 Jun 15;24(12):1253-65
Regulation of ICP0-null mutant herpes simplex virus type 1 infection by ND10 components ATRX and hDaxx.
Lukashchuk V, Everett RD
Journal of virology 2010 Apr;84(8):4026-40
Journal of virology 2010 Apr;84(8):4026-40
Herpes simplex virus type 1 genomes are associated with ND10 nuclear substructures in quiescently infected human fibroblasts.
Everett RD, Murray J, Orr A, Preston CM
Journal of virology 2007 Oct;81(20):10991-1004
Journal of virology 2007 Oct;81(20):10991-1004
No comments: Submit comment
Supportive validation
- Submitted by
- per
- Main image

- Experimental details
- Western blot analysis of antibody specificity using a routine panel composed of IgG/HSA-depleted human plasma and protein lysates from selected human tissues and cell lines.
- Validation comment
- Band of predicted size in kDa (+/-20%) with additional bands present.
- Primary Ab dilution
- 1:500
- Secondary Ab dilution
- 1:3000
- Lane 1
- Marker [kDa]: 220, 112, 84, 47, 32, 26, 16.8
- Lane 2
- RT-4
- Lane 3
- U-251MG sp
- Lane 4
- Human Plasma
- Lane 5
- Liver
- Lane 6
- Tonsil
- Theoretical target weight
- [kDa] 14
Supportive validation
- Submitted by
- per
- Main image
- Experimental details
- Immunohistochemical staining of human stomach shows strong nuclear positivity in glandular cells.
- Validation comment
- Two independent antibodies targeting one protein yielding similar staining patterns. Staining pattern consistent with experimental and/or bioinformatic data.